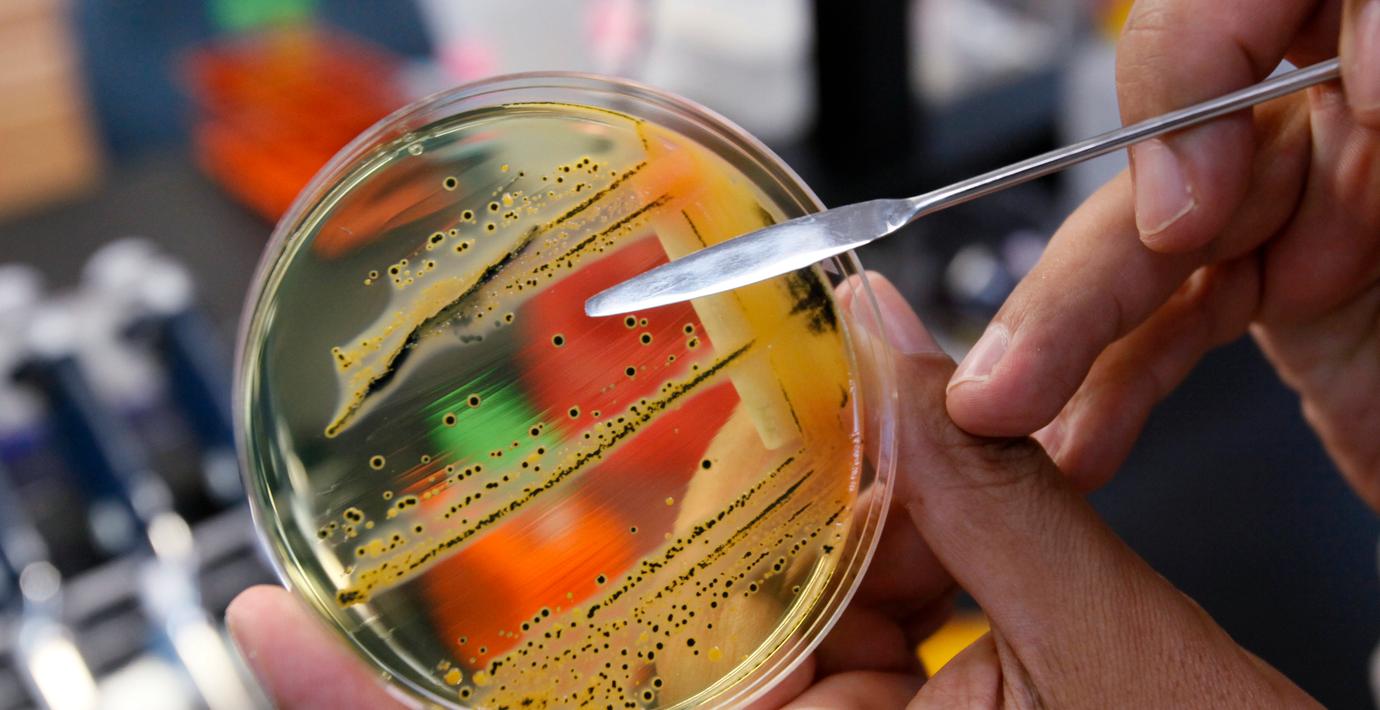

Ny vd i Investor-bolag
Chris Smith har utsetts till ny vd för Investors Laborie från och med 22 september. Han efterträder Michael Frazzette som valt att avgå efter åtta år i rollen, enligt ett pressmedd…
Få full tillgång till Omni Ekonomi
- Alla mediers affärsnyheter på ett ställe
- Upplåst innehåll från världens ledande medier
- Dagliga aktieanalyser direkt i appen
Omni är politiskt obundna och oberoende. Vi strävar efter att ge fler perspektiv på nyheterna. Har du frågor eller synpunkter kring vår rapportering? Kontakta redaktionen